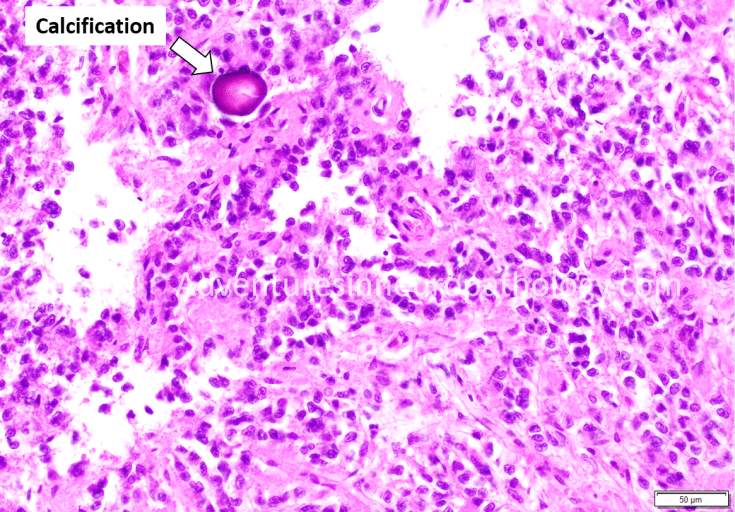
Normal Pineal gland with calcifications

The pineal gland is a midline structure involved in the regulation of circadian rhythm. The “internal clock” that allows for coordination of sleep and wake cycles with changes in night and day is largely regulated by the actions of melatonin, a neurotransmitter that is produced by the constituent cell of the pineal gland: the pinealocyte. Pinealocytes give rise to a rare group of tumors called pineal parenchymal tumors, which includes pineocytoma (grade 1) and pineoblastoma (grade 4). However, normal pinealocytes may be confused for a neoplastic process due to their nuclear features and nested architecture. The pineal gland commonly contains calcifications; in the era prior to MRI and CT scans, these calcifications were instrumental for radiologists’ diagnosis of midline shift because displacement of the midline pineal gland by a brain tumor or trauma could be detected on X ray.

Leave a comment